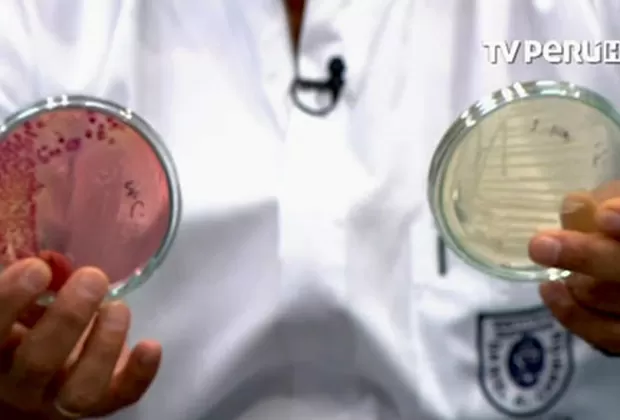
¿Tomas estas bebidas? Mira cuántas bacterias hay en su interior

¿Tomas estas bebidas? Mira cuántas bacterias hay en su interior
Pusieron a prueba de análisis este tipo de bebidas y los resultados fueron alarmantes. Un especialista te explica por qué deberías evitar su consumo

El calor del verano o la necesidad de alimentarnos con un desayuno al paso, puede llevarnos a comprar una bebida en la calle, sin darnos cuenta de cuáles pueden ser las consecuencias. ¿Sabes qué contienen estos líquidos envasados por manos libres?
Lee: [¿Cómo desinfectar frutas y verduras para evitar enfermedades?]
Jorge Sanamé, director del laboratorio clínico del Instituto Daniel A. Carrión, puso a prueba una botella de jugo de naranja y tras el análisis microbiológico, presentó los resultados alarmantes en el programa Marcando Agenda.
El especialista comprobó que el producto contiene bacterias, como la Escherichia coli (E.coli) y estafilococos, las cuales pueden ser “anómalas y agresivas” para los que consumen estas bebidas, ya causan problemas digestivos, como diarreas y fiebres intestinales.
“El problema no es la naranja en sí, son las botellitas que no tienen registros sanitarios, ni un control de calidad. Estas botellitas son manipuladas por personas en manos libres, pero ¿las botellas de dónde vienen?, ¿las han lavado? Es antihigiénico”, explica el director.
Lee: [¿Sufres de estreñimiento? Conoce las causas y cómo combatirlo]
La venta ambulatoria de estos refrescos propicia la mezcla del líquido con el smog, el polvo y otros gérmenes, los cuales además se mantienen y se envasan manualmente en botellas sin registro sanitario, lo que podría provocar la oxidación del contenido.
El especialista indica que los niños y los adultos mayores son los más vulnerables a problemas digestivos, debido a que su capacidad defensiva en el organismo es menor a la de un adulto:
“Cuando ingerimos alimentos tóxicos nos vuelve un poco vulnerables a las enfermedades. Si uno se enferma, bajan las defensas y ello nos expone a muchos agentes virales que hay en el ambiente, sobre todo en la época de altas temperaturas”.
Toma tus precauciones frente a estas bebidas y exige tanto los procedimientos de higiene necesarios al vendedor ambulante, como la fiscalización de parte de la municipalidad. Recuerda que podrás gastar 1 o 2 soles en un refresco, pero la salud no tiene precio.
Lee también: [¿Por qué amanezco con la boca amarga y seca?]





